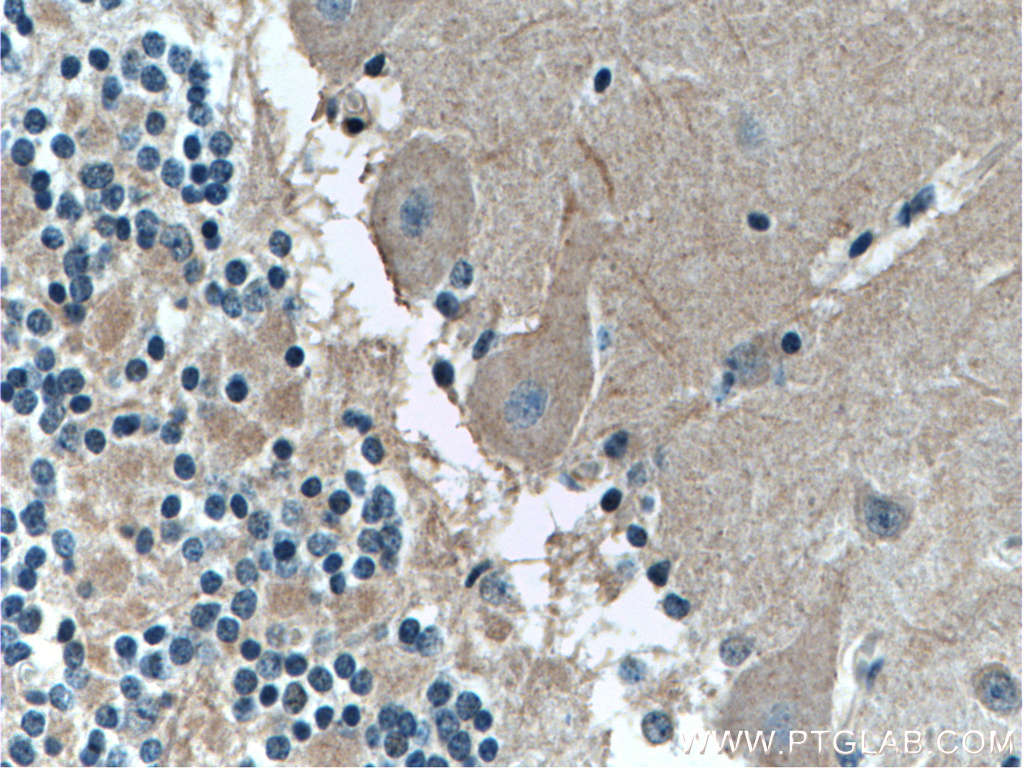

验证数据展示
产品信息
66054-1-PBS targets ARHGDIB in WB, IHC, IF-P, Indirect ELISA applications and shows reactivity with human, mouse, rat samples.
| 经测试应用 | WB, IHC, IF-P, Indirect ELISA Application Description |
| 经测试反应性 | human, mouse, rat |
| 免疫原 |
CatNo: Ag9091 Product name: Recombinant human ARHGDIB protein Source: e coli.-derived, PET28a Tag: 6*His Domain: 1-201 aa of BC009200 Sequence: MTEKAPEPHVEEDDDDELDSKLNYKPPPQKSLKELQEMDKDDESLIKYKKTLLGDGPVVTDPKAPNVVVTRLTLVCESAPGPITMDLTGDLEALKKETIVLKEGSEYRVKIHFKVNRDIVSGLKYVQHTYRTGVKVDKATFMVGSYGPRPEEYEFLTPVEEAPKGMLARGTYHNKSFFTDDDKQDHLSWEWNLSIKKEWTE 种属同源性预测 |
| 宿主/亚型 | Mouse / IgG2b |
| 抗体类别 | Monoclonal |
| 产品类型 | Antibody |
| 全称 | Rho GDP dissociation inhibitor (GDI) beta |
| 别名 | 3E7B7, GDIA2, GDID4, Ly GDI, Ly-GDI |
| 计算分子量 | 201 aa, 23 kDa |
| 观测分子量 | 27 kDa |
| GenBank蛋白编号 | BC009200 |
| 基因名称 | ARHGDIB |
| Gene ID (NCBI) | 397 |
| RRID | AB_11045657 |
| 偶联类型 | Unconjugated |
| 形式 | Liquid |
| 纯化方式 | Protein G purification |
| UNIPROT ID | P52566 |
| 储存缓冲液 | PBS only, pH 7.3. |
| 储存条件 | Store at -80°C. The product is shipped with ice packs. Upon receipt, store it immediately at -80°C |
背景介绍
ARHGDIB, also known as RhoGDI2, is a conserved member of the RhoGDI family and plays an important role in cell migrations. It regulates the GDP/GTP exchange reaction of the Rho proteins by inhibiting the dissociation of GDP from them, and the subsequent binding of GTP to them. It is mainly in hematopoietic, endothelial, and epithelial cells. It has been linked to tumorigenesis and metastasis. RhoGDI2 expression is downregulated in several cancer types, such as bladder, lung and lymphoma, but is upregulated in prostate and gastric cancer.